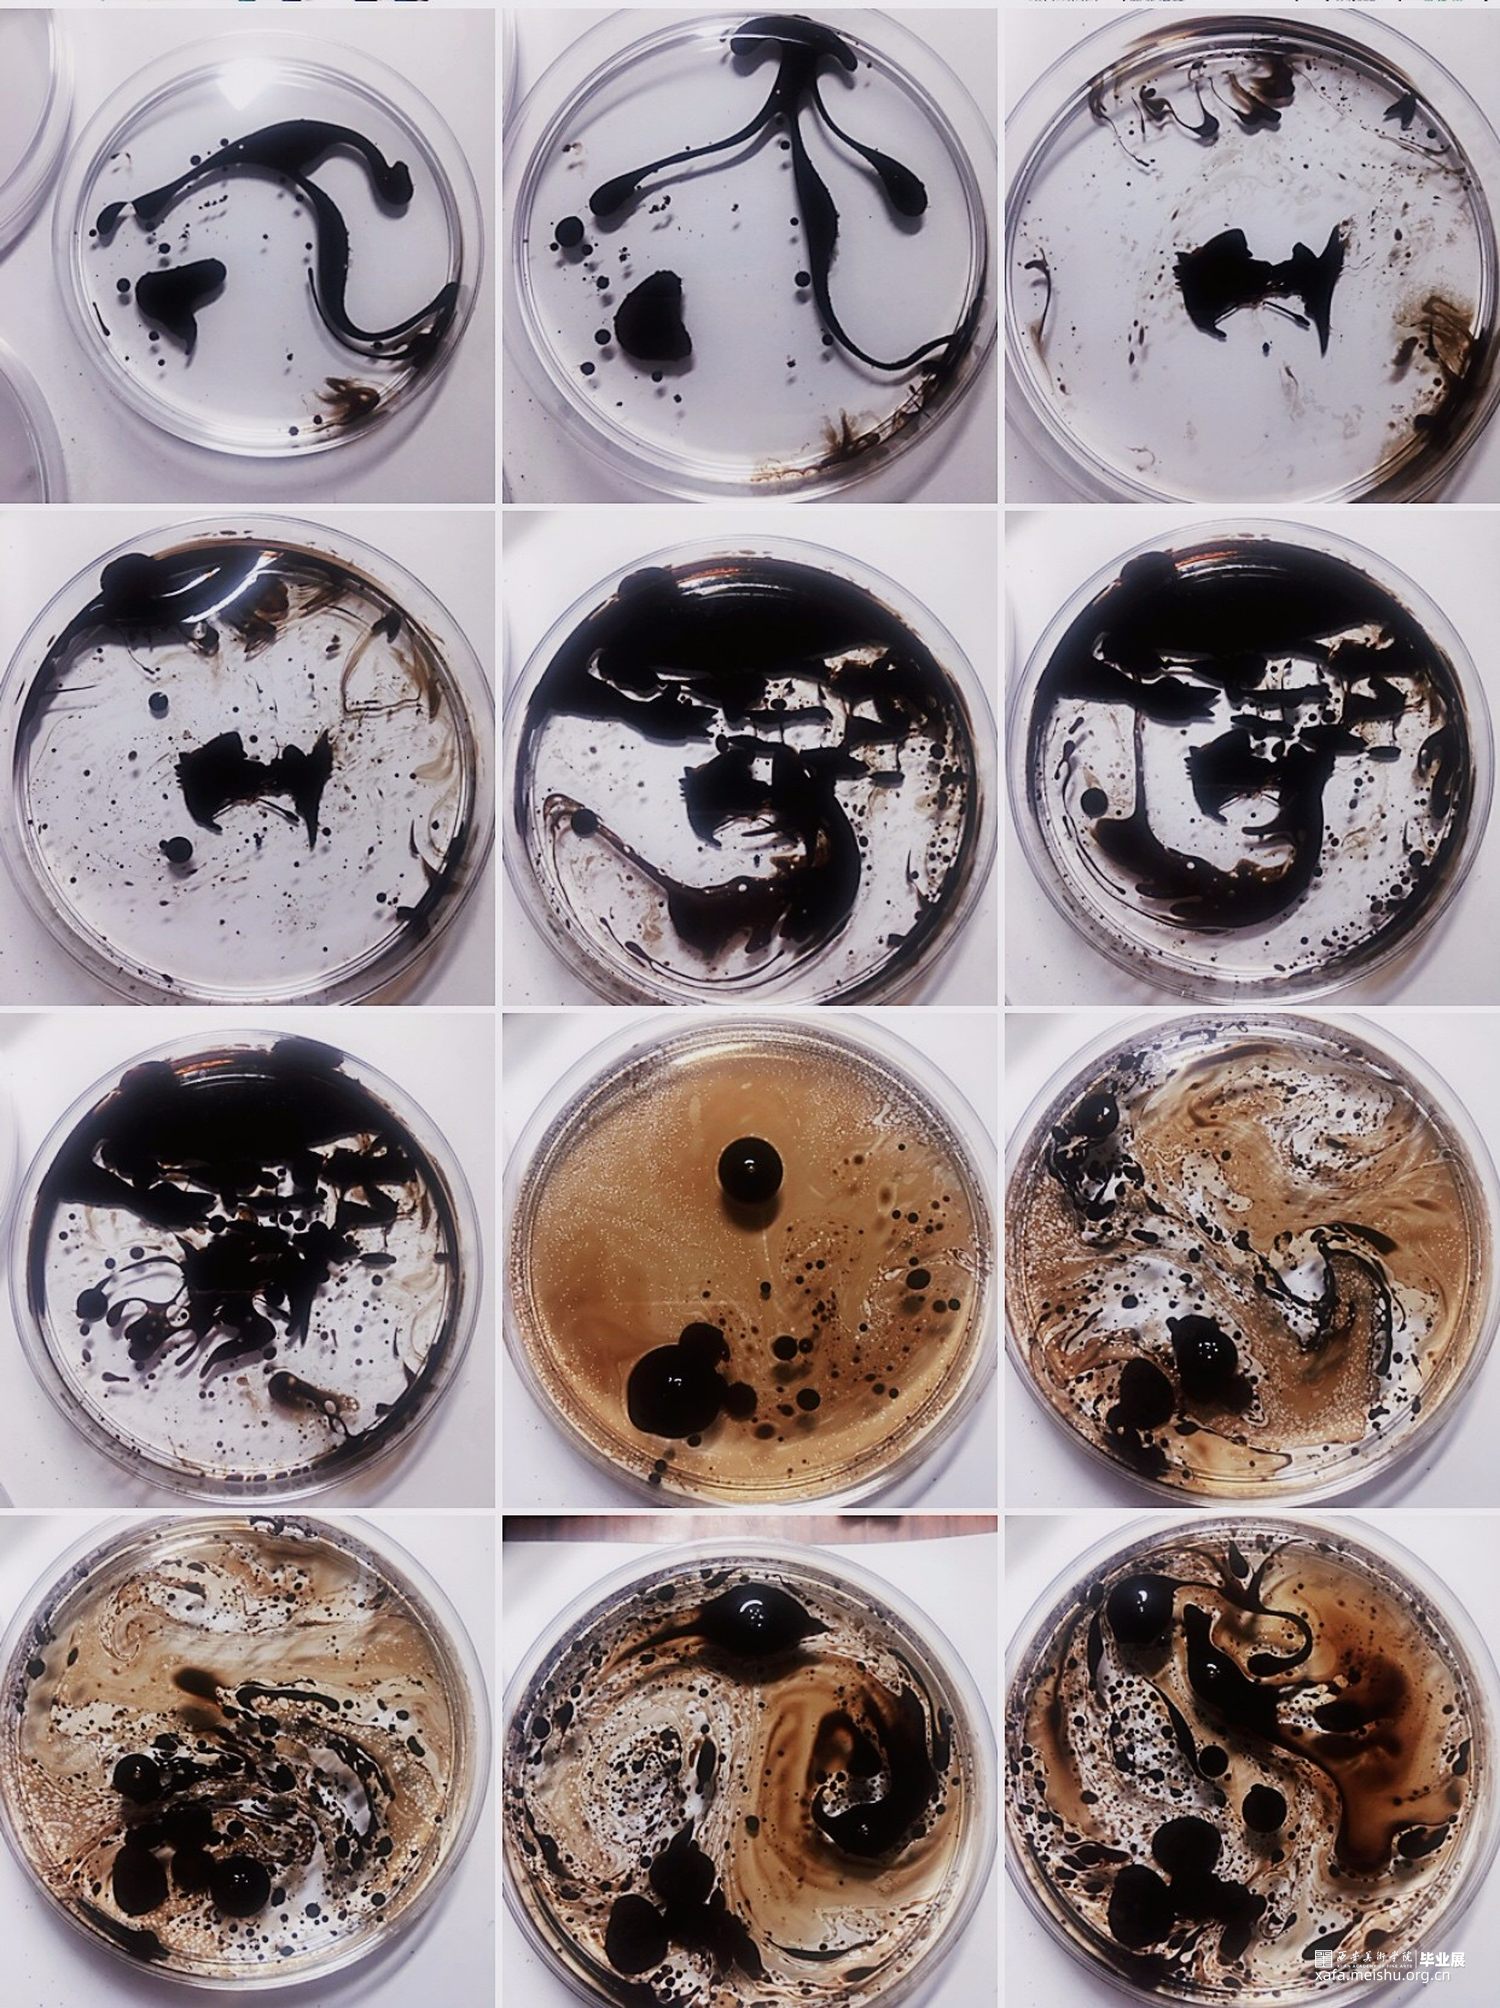

类别
装置
材质
其他
年代
2020
指导老师
李红军
描述
装置的主要材料是磁流体,磁流体作为一种工业材料,尝试把磁流体从机械里面抽取出来,将这种材料置于透明容器内部,磁流体在静态时无磁性吸引力,当外加磁场作用时才表现出磁性,正因如此作品利用磁流体这种黑色新型的功能材料表达如今现代生活的我们在本身平静的状态下会对受到外部环境的刺激影响,自身会表现出对生活复杂情绪等一系列的思考。